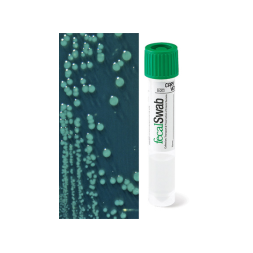
Сваб-система FecalSwab, велюр-тампон, САRY BLAIR, 2 мл, 12х80 мм

Пробирка вакуумная Rustech для гематологии, EDTA K3, 6 мл, 13х100 мм, фиолет., уп. 100 шт.
Возможно вас заинтересуют

артикул: И3ИП-568 остаток: нет в наличии
Шприц-вакцинатор, ПримаПлекс, Луер-Лок, 5 мл, трубка
цена формируется

артикул: И3ИП-617 остаток: нет в наличии
Шприц-вакцинатор, Сокорекс, Луер-Лок, 1 мл, под флакон
цена формируется

артикул: И3ИП-535 остаток: нет в наличии
Игла иньекц. Луер для птиц № 0,7х10, уп. 12 шт.
цена формируется
артикул: 1560 остаток: нет в наличии
Сваб-система FecalSwab, велюр-тампон, САRY BLAIR, 2 мл, 12х80 мм
цена формируется

артикул: И3ИП-514 остаток: нет в наличии
Игла иньекц. Луер для птиц № 0,6х13, уп.12шт
цена формируется

артикул: И3ИП-00028 остаток: нет в наличии
Игла инъекц. Луер-.лок № 1,2х30, 18G ПРЕМИУМ уп 12 шт,
цена формируется

артикул: 3710704 остаток: нет в наличии
Игла инъекционная, Луер-Лок, 0,7х4, 22G, для птиц, Сокорекс, 371.0704, упак. 12 шт.
цена формируется

артикул: И3ИП-491 остаток: нет в наличии
Игла иньекц. Луер для свиней и коров № 1,6х35, уп.12 шт
цена формируется

артикул: И3ИП-376 остаток: нет в наличии
Игла двухсторон. под вакуумн. пробирку Rustech, стерил. Для взятия крови, р-р 1,25х38
цена формируется

артикул: И3ИП-575 остаток: нет в наличии
Игла инъекционная Рекорд 1,5х30 VIC, упак. 12 шт
цена формируется

